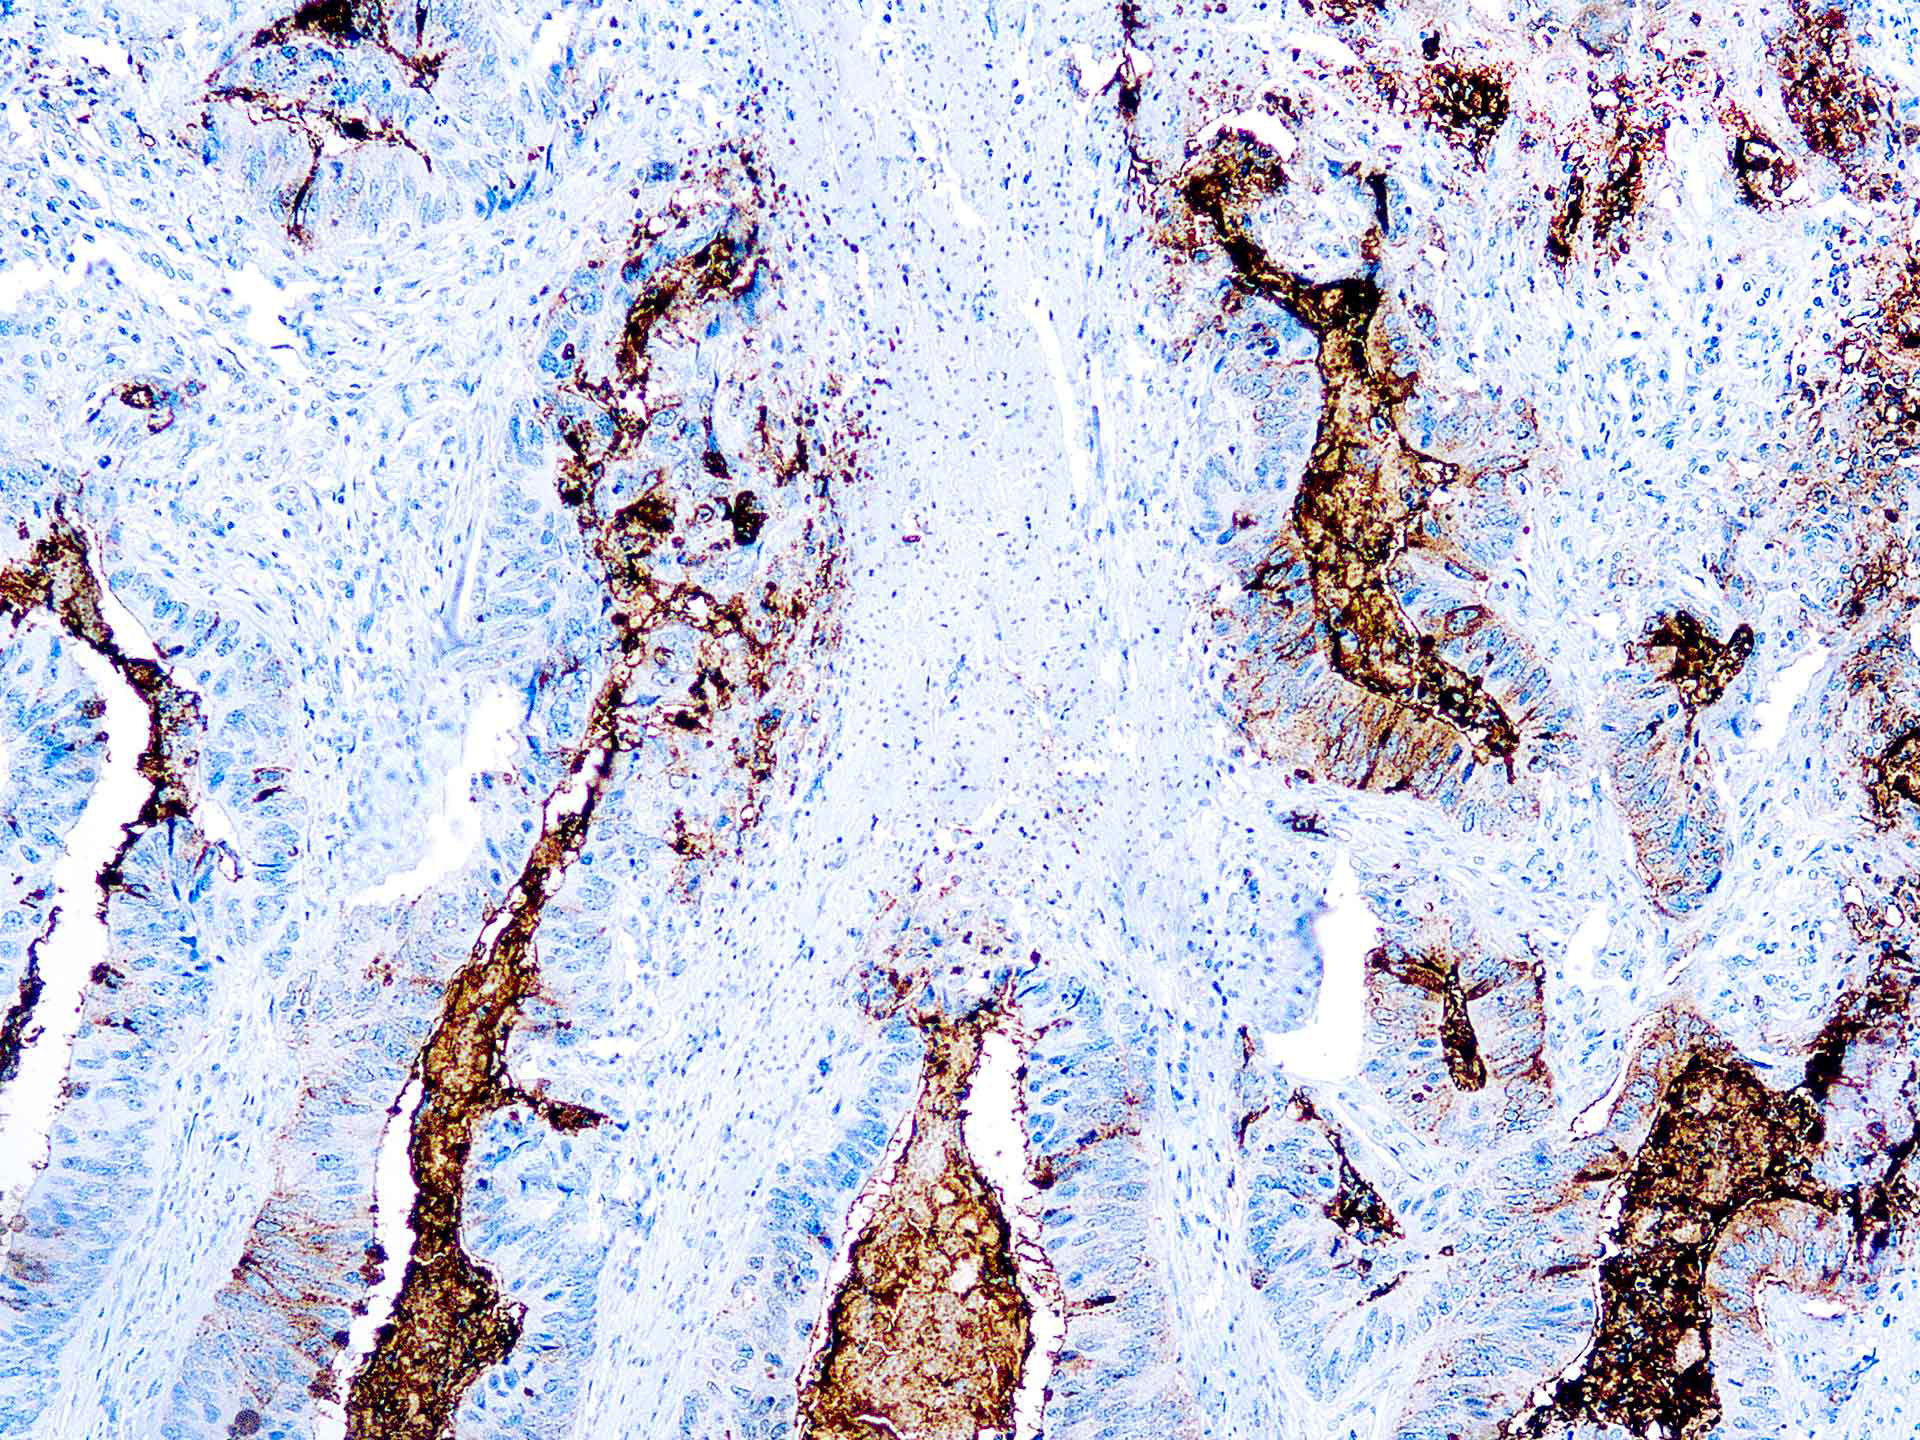

This antibody recognizes an oncofetal antigen of 220kDa, identified as a tumor-associated glycoprotein (TAG-72) with properties of a mucin. This antibody defined the mucin-carried sialylated-Tn epitope. TAG-72 is usually expressed by adenocarcinomas, but is negative in mesotheliomas. Studies have reported that this antibody has 80% sensitivity and 93% specificity for pulmonary adenocarcinoma. However, false positive reactions can occur so results must be interpreted with the utmost caution. This antibody may be useful in the differentiation of non-small cell carcinomas from small cell carcinomas of the lung. The combined use of anti-TAG-72 and anti-GCDFP15 is valuable in the diagnosis of apocrine carcinoma.
TAG-72 /CA 72-4 (B72.3)
SKU: Mob288-
Categories: Primary Antibodies, IVD - For U.S. Market, IVD - Outside U.S. Market
Tags: Highlighter Product, HL72K-Core Kit, Concentrated, T
Description
Additional information
| Catalog No. | Mob288 Concentrated, PDM100 Prediluted |
|---|---|
| Clone | B72.3 |
| Isotype | IgG1, kappa |
| Immunogen | Membrane enriched fraction of a human breast carcinoma liver metastasis. |
| Species | Mouse |
| Cellular Localization | cell surface, Cytoplasmic |
| Positive Control Tissue | Colon carcinoma |
| Pretreatment | Citrate Buffer pH 6.0 |
| Incubation & Temperature | 30 min @ RT |
| Intended Use | IVD |
| Detection System | PolyVue Plus – Two Step Detection System or Montage PolyVue Plus Auto Detection System for Montage 360 System |
| Description/Type | Mouse Monoclonal Antibody |
| Format | This product is supplied as a tissue culture supernatant and contains sodium azide as a preservative. |
DATASHEETS & SDS
DATASHEETS & SDS
| Download Datasheet |
| Download SDS Sheet – OSHA |
REFERENCES
REFERENCES
- Lottich SC et. al. Breast Cancer Research and Treatment, 1985, 6(1):49-56.
- Thor A et. al. Cancer Research, 1986, 46(6):3118-24
Reviews (0)
Only logged in customers who have purchased this product may leave a review.

Reviews
There are no reviews yet.